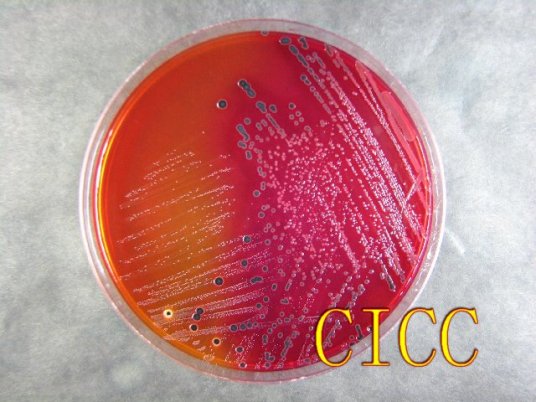
沙门氏菌食物中毒

食物中毒解决办法一般有催吐、导泻、药物治疗等。
1、催吐
食物中毒后,患者可以使用催吐的方法,尽量将食物吐出,减少毒素的吸收,从而缓解症状。
2、导泻
如果食物中毒的情况比较严重,患者可以在医生的指导下使用硫酸镁、甘露醇等药物进行导泻,促进毒素的排出,缓解症状。
3、药物治疗
如果患者出现腹痛、腹泻等症状,可以在医生的指导下使用阿托品、山莨菪碱等药物进行治疗,缓解症状。
除此之外,食物中毒还可以通过洗胃、补液等方法缓解。
建议患者平时注意饮食卫生,不要吃变质的食物,以免引起食物中毒。
标签:食物中毒